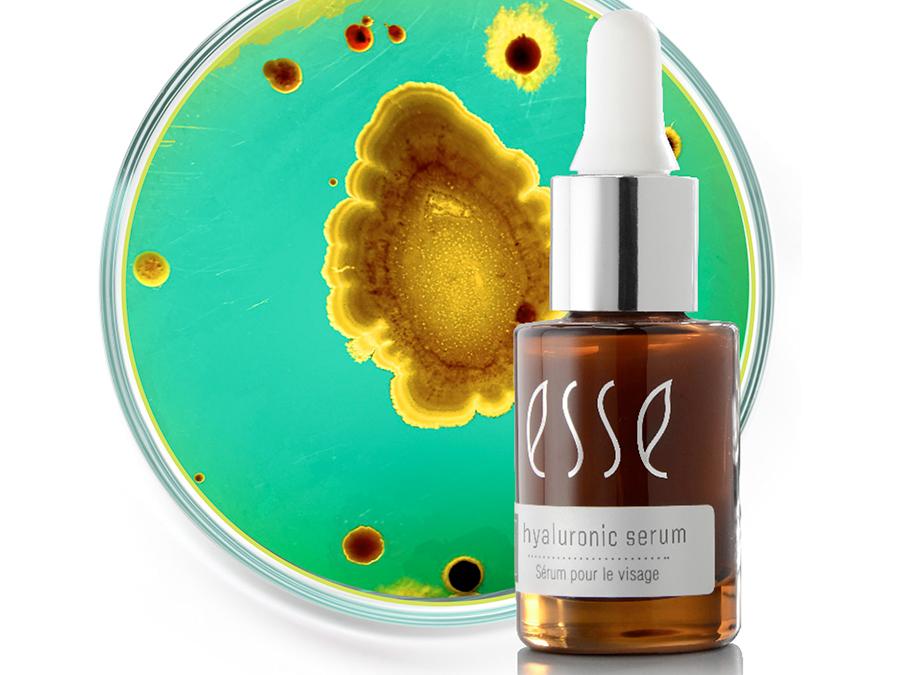
A small brown glass bottle labeled "Esse Hyaluronic Serum" with a white dropper cap is positioned in front of a green and yellow petri dish with various circular patterns, suggesting a scientific or skincare-related context.

How to Celebrate the Legacy of the “Father of Probiotic Skincare”
After the sudden, tragic loss of founder Trevor Steyn, Esse Skincare’s Lead Education Specialist, Alicia Stander, explains how to proceed, utilising his trailblazing approach to the skincare industry. Stander…